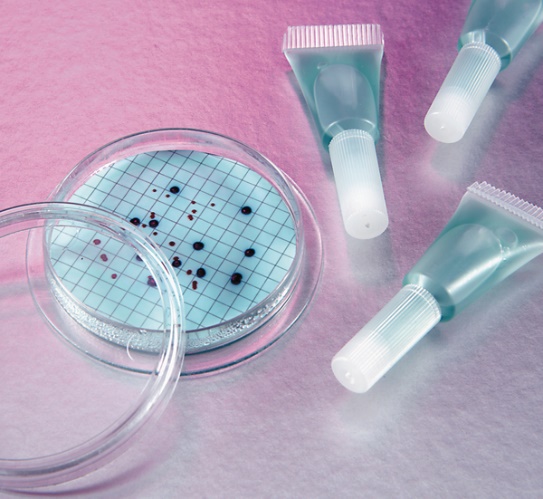

OMEGA PERU BLOG
30 de junio de 2022
BACTERIAS Y SUS MEDIOS DE CULTIVO
Los medios de cultivo constituyen la herramienta fundamental en los laboratorios de Microbiología. Desde la época de Koch hasta hoy en día se ha incrementado enormemente el arsenal de medios de cultivo con que cuentan los microbiólogos. La responsable directa de tal incremento es la expansión de la microbiología desde la medicina hacia la agricultura, la alimentación y la industria farmacéutica.
El conocimiento de la nutrición microbiana permite el cultivo de los microorganismos en el laboratorio. En general, todos los microorganismos tienen requerimientos de macro y micronutrientes semejantes, aunque la forma en que cada uno de ellos es captado y su cantidad relativa pueden variar mucho entre los diferentes géneros. En el laboratorio, el desarrollo de los microorganismos se realiza en medios de cultivos que son ambientes artificiales diseñados por el hombre para proporcionar todas las sustancias necesarias para el crecimiento microbiano.
Según la finalidad para la cual fueron formulados, se pueden clasificar en:
• Enriquecidos: Son medios complejos o sintéticos con aditivos adicionales para favorecer el crecimiento de determinados microorganismos (particularmente heterótrofos exigentes). Se adicionan al medio de cultivo sustancias nutritivas como azúcares, sangre, suero, extractos de tejidos de animales y plantas.
• Selectivos: Son aquellos que permiten por su diseño el crecimiento específico de un determinado microorganismo o grupo de estos e impiden en su mayoría el desarrollo de los demás. Son de gran utilidad para el aislamiento de microorganismos a partir de poblaciones microbianas mixtas. Se incorporan ciertas sustancias que otorgan la selectividad buscada al medio. Por ejemplo el agregado de lactosa, bilis, NaCl, azida, taurocolato, antibióticos, permite el desarrollo de un determinado grupo de microorganismos impidiendo el desarrollo de otros.
• Diferenciales: Son aquellos que permiten distinguir a simple vista dos o más tipos de bacterias en función de su distinto comportamiento respecto de algún nutriente del medio. Ese comportamiento diferencial se traduce normalmente en un viraje de color de una sustancia indicadora presente en el medio. Poseen en su composición un reactivo o sustancia química que al combinarse con algún producto del metabolismo origina una coloración característica. Por ejemplo, el desarrollo de E. coli en medio Endo da colonias rojas ya que la fucsina decolorada con bisulfito de sodio al combinarse con los aldehídos provenientes del metabolismo bacteriano de lactosa, imprime coloración roja a la colonia.
• Selectivos-Diferenciales: Representan una combinación de los dos últimos medios. Permiten el desarrollo de una bacteria o un tipo bacteriano y al mismo tiempo producen una coloración característica del organismo en estudio.
• Electivos: Favorecen el desarrollo de una especie bacteriana y las restantes crecen poco y lentamente
Cualquiera sea el tipo de medio, se pueden preparar para ser usados en estado líquido, sólido o semisólido. Los medios de cultivo líquidos se conocen como caldos y a partir de ellos, por el agregado de un agente solidificante estable (agar), se preparan medios de consistencia sólida o semisólida, que se denominan medios sólidos o agarizados. El gelificante más usado es el agar-agar en una concentración de 1,5-2% y 0,7% para el sólido y semisólido respectivamente. Presenta la gran ventaja que una vez gelificado, no funde hasta cerca de los 100oC, lo que permite su uso para la mayoría de las bacterias y además son muy pocos los microorganismos que lo hidrolizan (agarolíticos) como ocurre con la gelatina.
El medio de cultivo requiere una esterilización, inmediatamente después de su preparación, para eliminar los microorganismos contaminantes; esto se hace normalmente por calor húmedo a menos que en su composición, el medio contenga sustancias termolábiles.
Diagrama de preparación:

Como podemos ver, la preparación de un medio de cultivo no es tan simple, debe pasar por todo un proceso solo para estar en condiciones de ser utilizado. Es por ello que Hach nos ofrece toda una gama de este material básico en todo laboratorio de microbiología ya listo para usar. Uno se olvida de los pasos de medición, mezcla y autoclave necesarios para preparar medios deshidratados y utiliza directamente las ampollas de caldo sobre placas para cultivo solo segundos antes de hacer la inoculación de la bacteria. De esta manera el investigador ahorra tiempo mejorando su eficiencia. Las aplicaciones incluyen agua potable, aguas residuales, bebidas, aguas superficiales, subterráneas y de pozo, etc.
A continuación, los diferentes medios de cultivo que podemos encontrar con Hach:
• m-ColiBlue24: para coliformes totales y E. coli. En 24 horas, el caldo m-ColiBlue24® de Hach le ofrece resultados simultáneos para coliformes totales y E. coli. Las ampollas de vidrio, las ampollas de plástico, los frascos de 100mL de m-ColiBlue24® y las placas de agar, ofrecen la máxima vida útil y facilidad de uso de los medios y preparados. Diferencie fácilmente las colonias: el rojo y el azul indican coliformes totales y el azul especifica E. coli. Obtenga una recuperación óptima de los organismos estresados y lesionados.
• m-FC: para coliformes fecales.
• m-Green: para hongos y levaduras.
• m-TGE: para bacterias heterotróficas.
• mENDO: para coliformes totales con colonias de un brillo verdoso-oro. Para las muestras de agua potable, confirme con los tubos de caldo Lauryl Tryptose y Brilliant Green Bile Broth. Las muestras que resulten positivas para las bacterias coliformes totales deben analizarse posteriormente para detectar la presencia de coliformes fecales o E. coli utilizando el medio EC o el medio EC con MUG, respectivamente.

• Medio EC: para coliformes fecales, como prueba confirmativa.
• Verde brillante: para coliformes totales, como prueba confirmativa.
• Lauril triptosa: para coliformes totales, como prueba presuntiva por el método del número más probable.
Fuentes:
Burguet, N. y Castillo, L. (2013). Quality control of the culture media used in environmental monitoring of the classified production areas. Revista Cubana de Higiene y Epidemiología, 51(2), 155-160. Cuba.
Apella, M. y Araujo, P. (2005). Microbiología de agua. Conceptos Básicos. Libro Tecnologías solares para la desinfección y descontaminación del agua. Capítulo 2.
Conozca más sobre estos productos en la sección de Medios Preparados en la categoría de Suministros de Microbiología en nuestra web. Para más información, puede comunicarse con nosotros al 336-6523 o ventas@omegaperu.com.pe
Suscríbete a la lista de correos de Omega Perú para recibir información de eventos, aplicaciones y los últimos desarrollos tecnológicos.
